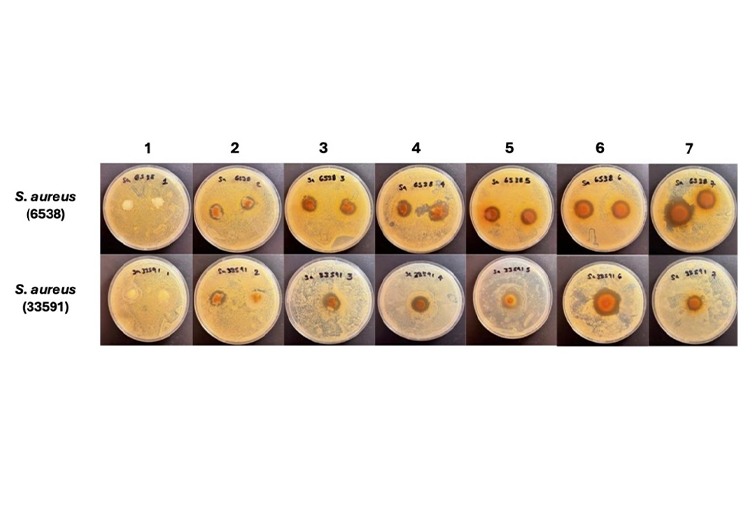

Aviso Importante: Actualización de Seguridad y Acceso
Estimada comunidad de la Revista Mexicana de Ciencias Agrícolas:
Para garantizar la protección de su información y cumplir con los protocolos institucionales de ciberseguridad, hemos implementado mejoras en nuestro sistema de acceso a la plataforma:
-
Nuevo método recomendado (ORCID): A partir de hoy, puede iniciar sesión de forma rápida y segura vinculando su cuenta de investigador mediante el botón ORCID.